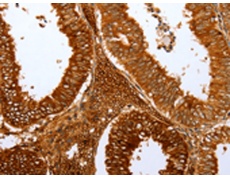
一抗

|
Background: |
Mutations in the winged-helix transcription factor gene at the nude locus in mice and rats produce the pleiotropic phenotype of hairlessness and athymia, resulting in a severely compromised immune system. This gene is orthologous to the mouse and rat genes and encodes a similar DNA-binding transcription factor that is thought to regulate keratin gene expression. A mutation in this gene has been correlated with T-cell immunodeficiency, the skin disorder congenital alopecia, and nail dystrophy. Alternative splicing in the 5' UTR of this gene has been observed. |
|
Applications: |
ELISA, IHC |
|
Name of antibody: |
FOXN1 |
|
Immunogen: |
Synthetic peptide of human FOXN1 |
|
Full name: |
forkhead box N1 |
|
Synonyms: |
WHN, RONU, FKHL20 |
|
SwissProt: |
O15353 |
|
ELISA Recommended dilution: |
1000-5000 |
|
IHC positive control: |
Human cervical cancer |
|
IHC Recommend dilution: |
25-100 |

 購物車
購物車 幫助
幫助
 021-54845833/15800441009
021-54845833/15800441009